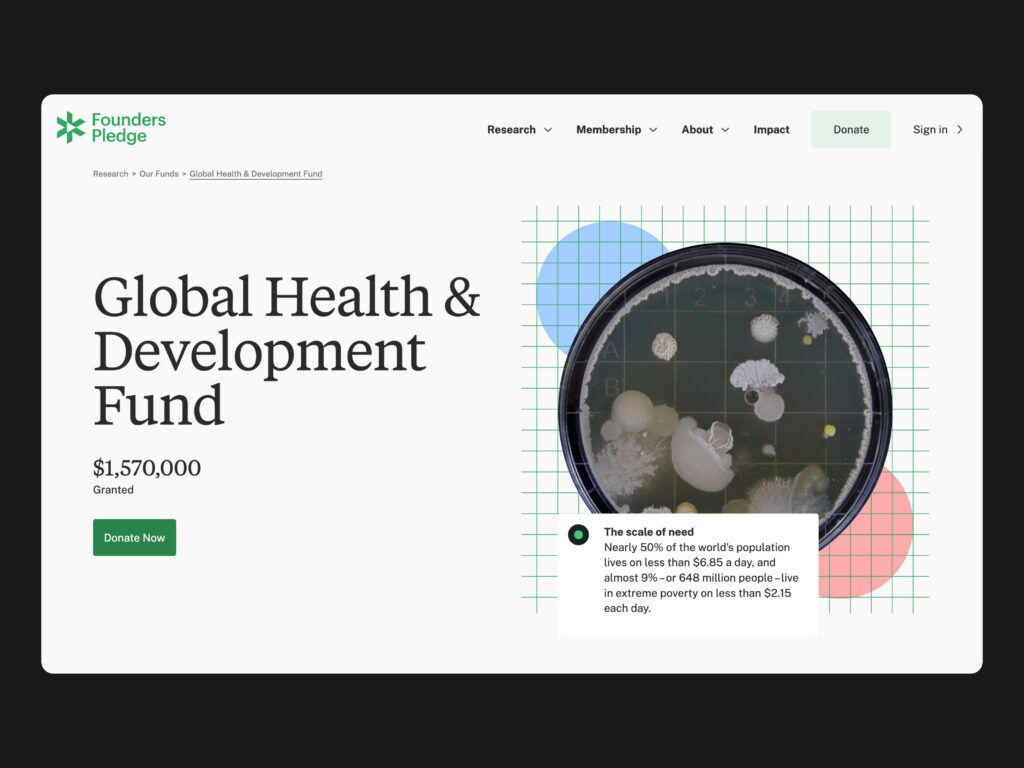

Founders Pledge
Founders Pledge maksimeerib heategevuse mõju, aidates tehnoloogiaettevõtjaid maailma suurimate probleemide lahendamisel. Nende liikmed on panustanud heategevuseks üle 10 miljardi dollari. Veebileht on tulevaste ja praeguste liikmete peamine kontaktikoht, mis pakub teavet protsessi ja liikmelisuse kohta. See toimib ka tööriistana, sisaldades mõjuaruanded ja ulatuslikku uuringute andmebaasi.